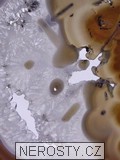
achát, plátek

plátek # 5544 z lokality Brazílie
Cena:5560 Kč, cca 229€
| achát |
|---|
| plátek |
| Šířka | 24 cm 9.5 ″ |
|---|---|
| Výška | 35.5 cm 14 ″ |
| Hmotnost | 1390 g 49.03 oz |
| Stát | Brazílie |
|
Objednáváte konkrétní vyfotografovaný kus. Při objednání obdržíte přesně to, co vidíte na obrázku. Vzorek si můžete osobně prohlédnout v naší prodejní galerii. Tento kus pochází z nabídky Nerosty.cz a je zde uveden proto, že se web zaměřuje na vzácné a sběratelsky hodnotné minerály. | |